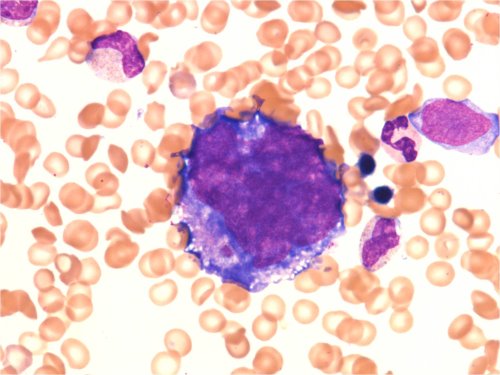
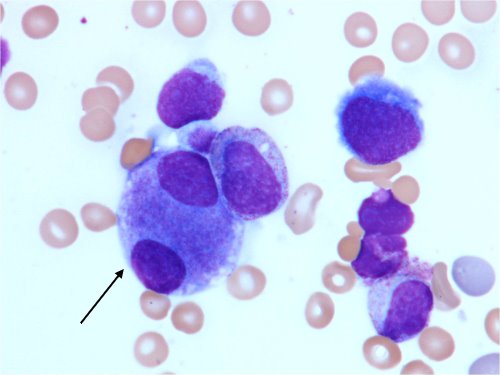

Normaali luuydin
Kuvatietokanta
20.6.2012 • Uusi artikkeli
Työryhmä: Ulla Pihkala, Pasi Huttunen, Minna Koskenvuo, Virve Pentikäinen, Samppa Ryhänen
Erytropoieesi
- Kehitysvaiheet
- Proerytroblasti
- Basofiilinen erytroblasti
- Polykromaattinen erytroblasti (pronormoblasti)
- Pyknoottinen erytroblasti (normoblasti)
- Retikulosyytti
- Kypsä punasolu
Megaloblastinen erytropoieesi
- Erytropoieesia sanotaan megaloblastiseksi tietyillä morfologisilla kriteereillä.
- Tilan ei tarvitse olla sairaus.
- Voi olla ohimenevä.
- Voi myös merkitä sairautta (esim. myelodysplastinen syndrooma).
Megaloblastisen erytropoieesin syitä
- Stressierytropoieesi yleensä
- Stressihematopoieesissa megloblastisia muutoksia on muissakin linjoissa, kuten myelopoieesissa. Solut ovat tuolloin tavallista suurempia.
- B12-vitamiinin ja foolihapon puute (lapsilla harvinainen)
- Sytostaattihoito ja siitä toipuminen
- Kantasolusiirrosta toipuminen
- Myelodysplastinen syndrooma
Megaloblastisen erytropoieesin piirteet
- Punasolujen esiasteet ovat suuria.
- Sytoplasman määrä suhteessa tuman kokoon on runsas.
- Tuman rakenne on löyhä, ja siinä on ns. parakromatiinia.
- Tuman kypsymishäiriö, eli tuma on jäljellä liian kypsissä soluissa (retikulosyytit, kypsät punasolut)
- Graaveina muutoksina voi olla monitumaisuutta ja tuman pirstoutumista.
Myelopoieesi
- Kehitysvaiheet
- Myeloblasti
- Promyelosyytti
- Myelosyytti
- Metamyelosyytti
- Neutrofiilinen, eosinofiilinen tai basofiilinen
- Sauvatumainen granulosyytti
- Neutrofiilinen, eosinofiilinen tai basofiilinen
- Liuskatumainen granulosyytti
- Neutrofiilinen, eosinofiilinen tai basofiilinen
Trombopoieesi
- Endomitoottinen synkroninen tuman replikaatio
- Tumien määrä kertautuu aina kahdella, ja sytoplasman volyymi kasvaa
Muita luuydinsoluja
- Kudosbasofiili
- Plasmasolu
- Osteoblasti
- Osteoklasti
Osteoblastit
- Osteoblastit rakentavat luuta.
- Ovat mesenkymaalista alkuperää eivätkä siis polveudu luuytimen kantasoluista.
- Sijaitsevat luutrabekkeleiden reunoilla.
- Löytyvät parhaiten luuydinbiopsian touch-preparaateista.
- Muistuttavat plasmasolua, koska sytoplasma on basofiilinen ja tuma eksentrinen.
- Osteoblasti on pitkänomaisempi, ja vaalea ”piha” (Golgin laite) ei ole tuman kyljessä vaan kauempana sytoplasmassa.
Osteoklastit
- Resorboivat luuta.
- Löytyvät vain luuydinbiopsianäytteistä ja touch-preparaateista.
- Isoja monitumaisia soluja, muistuttavat megakaryosyyttejä, mutta tumat irrallaan toisistaan ja sytoplasman granula karkeaa.
- Osteoklastien puute tai toimimattomuus aiheuttaa synnynnäisen osteopetroosi-taudin.
- Koska osteoklasti polveutuu luuytimen kantasolusta, osteopetroosi on korjattavissa allogeenisella kantasolusiirrolla.
Luuytimen rautavärjäys
- Lapsen normaalissa luuytimessä on yleensä hyvin vähän kudosrautaa, ja rautavärjäys on negatiivinen.
- Kudosrauta on lisääntynyt ja siis rautaa nähtävissä luuytimen rautavärjäyksessä tiloissa, joissa kehittyy esim. transfuusiosideroosi.
- Kudosrautaa on nähtävissä luuydinbiopsiassa sekä stroomassa tippavärjäyslasin keskiosassa.
Kuvat: Kuvattu 03–04/2012 HYKS/Lastenklinikan potilaiden 30 vuoden arkistomateriaalista. Kuvia käytettäessä on lähde ja tekijät mainittava.